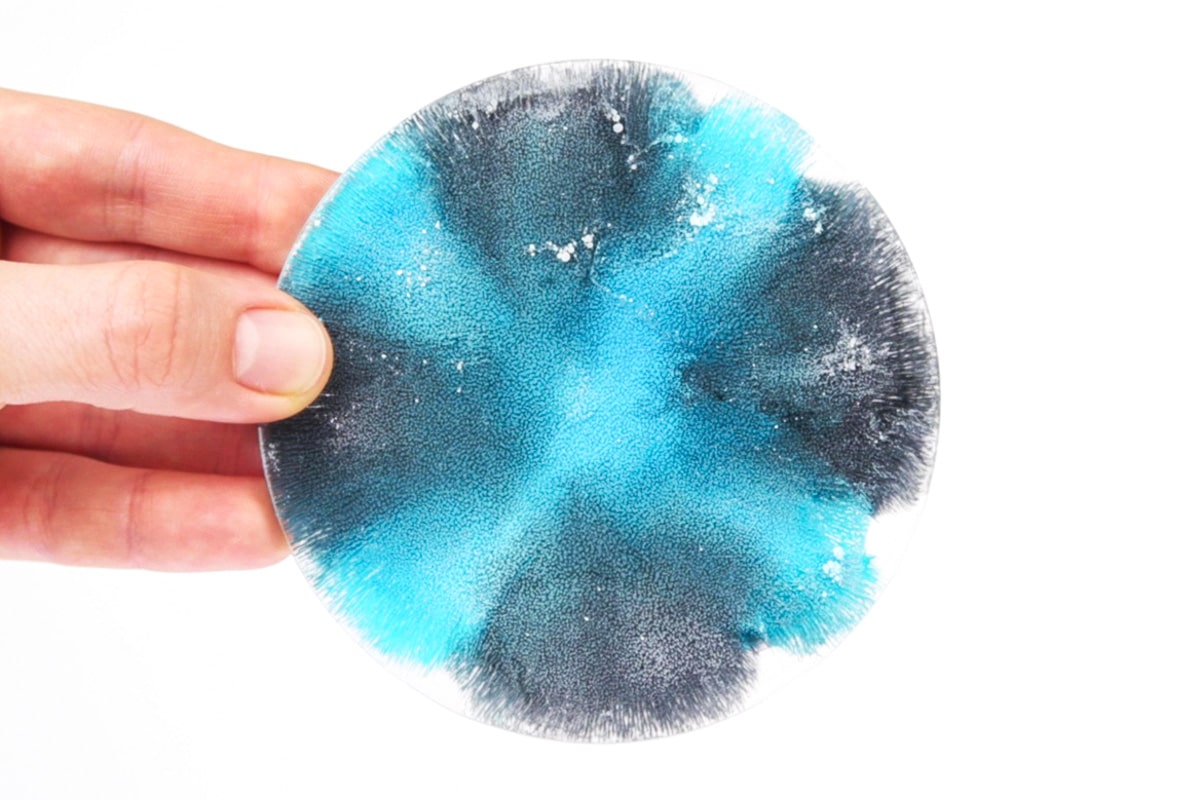
MwS_alcohol-ink-epoxy-Zircon-Blue

EPODEX Alcohol Ink in Blue
EPODEX Alcohol Inks are transparent and fast-drying alcohol-based ink colors specifically designed for fluid painting techniques. Create individual color gradients, abstract effects, and surprising shapes with EPODEX Alcohol Inks.
The ink can be used on almost all smooth, non-porous materials. Epoxy resins, synthetic papers (e.g. Yupo paper), glass, metal, ceramics, porcelain, stone or modeling clay are best suited. After drying, the acid-free Alcohol Inks are smudge-proof and waterproof.
Application on epoxy resins
- Mix epoxy resin and hardener in the specified mixing ratio.
- Pour the resin-hardener mixture onto the desired surface or into the desired mold. For the typical Alcohol Ink effect (“Petri-Art effect“) we recommend a maximum pouring height of 19/32”.
- Drop the Alcohol Ink “ZIRCON BLUE” onto the wet resin-hardener mixture.
- Add a drop of the Alcohol Ink “SELENIT WHITE” to the colored dye (“ZIRCON BLUE”). The colors displace each other and create an individual pattern. The more white drops you put on the colored drop, the deeper the colors sink into the resin and the stronger the Alcohol Ink effect is.
- To achieve a full-surface result, you can, for example, place several colored drops next to each other and alternate them with white drops to create a pattern.
- Work with different colored paints for a multicolored result.
Note: Please note that due to different lighting conditions and monitors, the colors may not be uniformly displayed. All information is recommendations based on our experience; without legal obligation.
Customer Service: If you have further questions, please contact us by phone, e-mail or use our WhatsApp support.